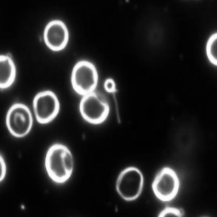
Refer to caption

Semantic Segmentation Alternative Technique:
Segmentation Domain Generation
Abstract
Detecting objects of interest in images was always a compelling task to automate. In recent years this task was more and more explored using deep learning techniques, mostly using region-based convolutional networks. In this project we propose an alternative semantic segmentation technique making use of Generative Adversarial Networks. We consider semantic segmentation to be a domain transfer problem. Thus, we train a feed forward network (FFNN) to receive as input a seed real image and generate as output its segmentation mask.
1 Introduction
The problem of automatic detection and segmentation of objects in images can be encountered in many domains, from sports to medicine or physics Rühle et al. (2021). Traditionally, one or more human experts would be required to perform live detection and give their expertise on the objects of interest location. Thus, automating this process was and still is considered of great value.
In this project we propose a general method for automating the process of segmentation of desired objects in an image, as displayed in Figure 1. Our method is based on Generative Adversarial Networks (GANs) (Goodfellow et al., 2014).
In recent years, the most successful methods for object segmentation were based on region proposal techniques such as R-CNN or Fast R-CNN (Girshick et al., 2015; Girshick, 2015). Even though such techniques achieve high performance on many benchmark datasets, they reveal two specific drawbacks. First, they tend to run slower than a simple FFNN, even after their training phase. Second, as most deep learning techniques, they need large training datasets.
We propose to treat the segmentation problem as a domain transfer task. The source domain is represented by the real images to be segmented and the target domain is represented by the segmentation masks. By doing so, we can adapt established techniques for image translation such as Conditional Generative Adversarial Networks (CGAN) and Cycle-Consistent Generative Adversarial Networks (CycleGAN) Isola et al. (2017); Zhu et al. (2017) for segmentation masks generation.
By using GANs for learning how to generate a segmentation mask we seek to address both aforementioned issues of the region proposal techniques. First, since after the training phase we make use only of the GAN’s generator, the segmentation generation time is equal to that of a forward pass through a FFNN. Second, both the CGAN and the CycleGAN revealed favorable results on relatively small datasets, with under samples, for example on the CMP Facades dataset, as shown in Isola et al. (2017); Zhu et al. (2017).
2 Datasets
We seek to validate our methodology by testing it on two datasets. The first dataset Particles contains images of particles acquired using electron microscopy (Rühle et al., 2021). Each image has an associated segmentation mask corresponding to the location of the particles. The second dataset Bacteria contains images of the Spirochaeta bacteria acquired using darkfield microscopy111https://www.kaggle.com/longnguyen2306/bacteria-detection-with-darkfield-microscopy. The location of the bacteria is marked with a corresponding segmentation mask.
3 Experiments
We led experiments on both datasets using CGANs and CycleGANs. For all the experiments we splitted our datasets in train and test sets. For Particles, samples for training and samples for testing. For Bacteria, samples for training and samples for testing.
3.1 Conditional GAN
We have tested a CGAN composed of a U-Net Ronneberger et al. (2015) generator and a Convolutional Neural Network (2D-Conv) discriminator. The model was trained for epochs. The last few epochs revealed stabilized values for the loss functions for both generator and discriminator. Thus, epochs were enough for reaching a Nash Equilibrium between the generator and the discriminator on the analyzed datasets. We can see the CGAN results in Figure 2.
![]() |
![]() |
![]() |
![]() |
![]() |
![]() |
3.2 Cycle GAN
We used the same U-Net generator and 2D-Conv discriminator when using the CycleGAN, as for the above mentioned experiments for the CGAN.
The image translation problem setting has two main changes when using a CycleGAN compared to using a CGAN. First, a CycleGAN does not need (image, mask) pairs for the translation. It is enough to have a number of samples from a source Domain A and a number of samples from a target Domain B, whereas a CGAN requires perfect pairs between the two domains. Second, for a CycleGAN we have to train four discriminators and one generator. Thus the training procedure is more laborious.
We have observed that the results of a trained CycleGAN are inferior to those obtained by a trained CGAN as we can see in Figure 3. Since a CycleGAN does not take into account the (image, mask) pairs, it is to be expected that the generations should be affected in quality.
![]() |
![]() |
![]() |
![]() |
![]() |
![]() |
4 Conclusions and Future Work
We have shown in our preliminary experiments that indeed the segmentation problem can be treated as a domain transfer task and we proved our concept by using two types of generative networks, CGANs and CycleGANs on the Particles and Bacteria datasets.
In our future experiments we aim to compare established segmentation techniques against our method and compare them on multiple metrics, such as generator’s veracity when using a small training set, as well as segmentation generation speed.
Moreover, we wish to investigate the feasibility of the reverse problem. Mainly, the plausibility of generating true images from segmentation masks. There are multiple domains where the possibility of generating real images from categorical masks would represent a real asset.
References
- Girshick (2015) Ross Girshick. 2015. Fast r-cnn. In Proceedings of the IEEE international conference on computer vision, pages 1440–1448.
- Girshick et al. (2015) Ross Girshick, Jeff Donahue, Trevor Darrell, and Jitendra Malik. 2015. Region-based convolutional networks for accurate object detection and segmentation. IEEE transactions on pattern analysis and machine intelligence, 38(1):142–158.
- Goodfellow et al. (2014) Ian J Goodfellow, Jean Pouget-Abadie, Mehdi Mirza, Bing Xu, David Warde-Farley, Sherjil Ozair, Aaron Courville, and Yoshua Bengio. 2014. Generative adversarial networks. arXiv preprint arXiv:1406.2661.
- Isola et al. (2017) Phillip Isola, Jun-Yan Zhu, Tinghui Zhou, and Alexei A Efros. 2017. Image-to-image translation with conditional adversarial networks. In Proceedings of the IEEE conference on computer vision and pattern recognition, pages 1125–1134.
- Ronneberger et al. (2015) Olaf Ronneberger, Philipp Fischer, and Thomas Brox. 2015. U-net: Convolutional networks for biomedical image segmentation. CoRR, abs/1505.04597.
- Rühle et al. (2021) Bastian Rühle, Julian Frederic Krumrey, and Vasile-Dan Hodoroaba. 2021. Workflow towards automated segmentation of agglomerated, non-spherical particles from electron microscopy images using artificial neural networks. Scientific reports, 11(1):1–10.
- Zhu et al. (2017) Jun-Yan Zhu, Taesung Park, Phillip Isola, and Alexei A Efros. 2017. Unpaired image-to-image translation using cycle-consistent adversarial networks. In Proceedings of the IEEE international conference on computer vision, pages 2223–2232.